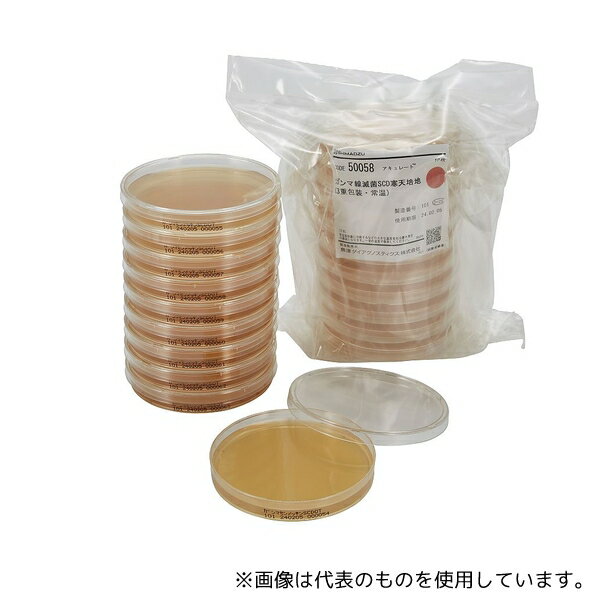
島津ダイアグノスティクス 50058 アキュレート？ガンマ線SCD寒天培地(3重包装・常温) 100枚

「花・ガーデン・DIY」の商品をご紹介します。

【AS ONE】分析・特殊機器|培地等Merck 1.00467.0500 ローズベンガル クロラムフェニコール寒天培地(RBC 寒天培地) 微生物学用 100467 500G
【アズワン AS ONE】分析・特殊機器 培養機器・容器 培地等 商品の仕様 ●※国内外の在庫状況により納期が表記と異なる事がございますことご了承ください。 ●JANコード:4022536698410 【※ご注意ください】商品は代表の画像を使用しています。
56760 円 (税込 / 送料込)

【AS ONE】分析・特殊機器|分析機器その他●栄研化学 E-MC60 パールコア ミュラーヒントンS寒天培地
【アズワン AS ONE】分析・特殊機器 分離・分析ロシ 分析機器その他 ●CLSI Documentに準じた薬剤感受性試験用 商品の仕様 ●顆粒 ●内容量:300g ●JANコード:4987026117232 【※ご注意ください】商品は代表の画像を使用しています。
10615 円 (税込 / 送料込)

【AS ONE】分析・特殊機器|分析機器その他栄研化学 E-MS98 ポアメディアViカンジダ寒天培地 10枚入
【アズワン AS ONE】分析・特殊機器 分離・分析ロシ 分析機器その他 ●発色色素によるカンジダ属の主要5菌種の選択分離用 商品の仕様 ●生培地 ●内容量:10枚 ●JANコード:4987026216171 【※ご注意ください】商品は代表の画像を使用しています。
3146 円 (税込 / 送料別)
【AS ONE】分析・特殊機器|分析機器その他島津ダイアグノスティクス 50058 アキュレート?ガンマ線SCD寒天培地(3重包装・常温) 100枚
【アズワン AS ONE】分析・特殊機器 分離・分析ロシ 分析機器その他 ●日本薬局方準拠培地 ●一般細菌用 商品の仕様 ●入数:100枚 ●重量:4000g ●※保存方法:2~25℃(常温) ●有効期限:製造後6ヶ月 ●★1枚あたりのサイズ:蓋φ89.5×全高14.5mm ●JANコード:4987302500581 【※ご注意ください】商品は代表の画像を使用しています。
28600 円 (税込 / 送料込)

★ポイント最大16倍★お気軽にお見積もりご依頼下さい!★ポイント最大16倍★【全国配送可】-生培地 ポアメディア CP加ポテトデキストロース寒天 1パック(10枚入) 栄研化学 型番 8-MR31 JAN 4987026159508 aso 61-9627-94 ●在庫品 納期約 3営業日-【医療・研究機器】
●生培地●内容量:10枚●貯蔵方法:2~10℃ ●広告文責:株式会社コール・ミー 03-3533-9699 ●医療機具登録番号 ●商品品番 aso 61-9627-94 ●JAN 4987026159508 ●メーカー型番 8-MR31★事業者向け商品です。研究 実験 測定 検査 実験設備 保管 ライフサイエンス 分析 容器 コンテナー 実験器具 材料 備品 滅菌 清掃 安全保護用品 クリーン環境関連機器 ナビス navis アズワン asone axel Oversea Shipping EMS FedEx DHL ★お見積りはこちらから★ aso更新日 2025/10/31★月島堂はインボイス対応済!インボイスのご請求書、領収書をご発行可能です。★業界最安値に挑戦!専門店ならではの納得価格。★創業28年の信頼と実績!★多くのお客様に選ばれ、累積受注件数35000件突破!★月島堂は90%以上のお客様にご納得いただいております。★お気軽にお見積もりご依頼下さい★お見積りはこちらから★
1228 円 (税込 / 送料別)

★ポイント最大16倍★お気軽にお見積もりご依頼下さい!★ポイント最大16倍★【全国配送可】-粉末培地(ボトル) ESコリマーク 寒天培地 栄研化学 型番 E-KW12 JAN 4987026159126 aso 61-9627-24 ●在庫品 納期約 7営業日-【医療・研究機器】
●粉末●内容量:300g●貯蔵方法:室温保存 ●広告文責:株式会社コール・ミー 03-3533-9699 ●医療機具登録番号 ●商品品番 aso 61-9627-24 ●JAN 4987026159126 ●メーカー型番 E-KW12★事業者向け商品です。研究 実験 測定 検査 実験設備 保管 ライフサイエンス 分析 容器 コンテナー 実験器具 材料 備品 滅菌 清掃 安全保護用品 クリーン環境関連機器 ナビス navis アズワン asone axel Oversea Shipping EMS FedEx DHL ★お見積りはこちらから★ aso更新日 2025/10/31★月島堂はインボイス対応済!インボイスのご請求書、領収書をご発行可能です。★業界最安値に挑戦!専門店ならではの納得価格。★創業28年の信頼と実績!★多くのお客様に選ばれ、累積受注件数35000件突破!★月島堂は90%以上のお客様にご納得いただいております。★お気軽にお見積もりご依頼下さい★お見積りはこちらから★
28325 円 (税込 / 送料込)

分析・特殊機器/分離・分析ロシ/分析機器その他ベクトン・ディッキンソン BD BBL(TM) TSA5%ヒツジ血液寒天培地/バシトラシン添加チョコレート寒天培地 20枚 1個(1本×20枚入) 251789
ベクトン・ディッキンソン BD BBL(TM) TSA5%ヒツジ血液寒天培地/バシトラシン添加チョコレート寒天培地 20枚 1個(1本×20枚入)●本培地は、1枚で2種類の培地が併用できる様に組み合わされた便利で効率の良い培地で、発育性、溶血反応にすぐれた一般分離用TSA II5%ヒツジ血液寒天培地と、Haemophilus を選択的に分離できるバシトラシン添加チョコレートII 寒天培地との組み合わせです●生培地(分画培地)●入数:20枚入
7797 円 (税込 / 送料別)

あす楽対応、希少理化学衛生用品培養用高品質寒天 500g BA-30 1個
超精密ろ過により不活性の不純物を除去してあるため透明度が高く、無機イオン含量の低い寒天培地が得られます。 ・アガロース含量が高く耐熱性に優れています。殆どの配合培地に使用できます。型番:BA-30 ・内容量(g):500 ・水分:≦12.0% ・pH(1.5%溶液、80℃):7.0±0.4 ・ゲル強度(1.5%溶液):800±20g/cm2 ・粘度(1.5%溶液、85℃):7.5±1.0cP ・ゲル化温度:36.0±2.0℃ ・融点:91.0±2.0℃ ・透明度:≧96.0% ・灰分:≦1.5% ・Sulfate:≦0.8% ・Ca:≦0.3% ・Fe:≦60ppm ・粒度:100 mesh pass超精密ろ過により不活性の不純物を除去してあるため透明度が高く、無機イオン含量の低い寒天培地が得られます。 ・アガロース含量が高く耐熱性に優れています。殆どの配合培地に使用できます。型番:BA-30 ・内容量(g):500 ・水分:≦12.0% ・pH(1.5%溶液、80℃):7.0±0.4 ・ゲル強度(1.5%溶液):800±20g/cm2 ・粘度(1.5%溶液、85℃):7.5±1.0cP ・ゲル化温度:36.0±2.0℃ ・融点:91.0±2.0℃ ・透明度:≧96.0% ・灰分:≦1.5% ・Sulfate:≦0.8% ・Ca:≦0.3% ・Fe:≦60ppm ・粒度:100 mesh pass
18885 円 (税込 / 送料込)

島津ダイアグノスティクス粉末培地顆粒タイプトリプトソーヤ寒天培地(SCD寒天培地)300g
用途:一般細菌用日本薬局方準拠培地 入数:内容量:300g製品サイズ:9cm*9cm*19cm 保存方法:室温防湿使用期限:製造より3年 重量:438g ※事業者向け商品です。ご使用後の培地類は、速やかにオートクレーブ滅菌後、地方自治体または国の法規に準拠し、安全に処分してください。
8401 円 (税込 / 送料別)
![■TKG デンサン 18-0寒天切 背止付(細目) 中 BKV05002(1887624)[送料別途見積り][法人・事業所限定][掲外取寄]](https://thumbnail.image.rakuten.co.jp/@0_mall/first34/cabinet/1887/trusco-1887624.jpg?_ex=128x128)
遠藤商事 調理器具■TKG デンサン 18-0寒天切 背止付(細目) 中 BKV05002(1887624)[送料別途見積り][法人・事業所限定][掲外取寄]
オレンジブック トラスコ中山 TRUSCOTKG デンサン 18-0寒天切 背止付(細目) 中 〔品番:BKV05002〕[ 注番:1887624]特長仕様仕様2●サイズ:中●目幅:細目●全長×刃渡り×幅(mm):258×181×38●材質:18-0ステンレス材質/仕上セット内容/付属品注意原産国(名称)日本JANコード4562202950287本体質量65gオレンジブック トラスコ中山 TRUSCOTKG デンサン 18-0寒天切 背止付(細目) 中 〔品番:BKV05002〕[注番:1887624][本体質量:65g]《包装時基本サイズ:260×40×3》〔包装時質量:55g〕分類》研究用品》厨房用品》調理器具☆納期情報:メーカー取り寄品(弊社より発送)
1133 円 (税込 / 送料別)

【AS ONE】分析・特殊機器|分析機器その他栄研化学 E-KW03 粉末培地(ボトル顆粒) パールコア(R) ESサルモネラ寒天培地II
【アズワン AS ONE】分析・特殊機器 分離・分析ロシ 分析機器その他 ●硫化水素非産生のサルモネラ属菌分離用 商品の仕様 ●顆粒 ●内容量:300g ●JANコード:4987026159027 【※ご注意ください】商品は代表の画像を使用しています。
39160 円 (税込 / 送料込)

【AS ONE】分析・特殊機器|分析機器その他ベクトン・ディッキンソン 251536 BD BBL(TM) 標準寒天培地 1個(1本×20枚入)
【アズワン AS ONE】分析・特殊機器 分離・分析ロシ 分析機器その他 ●一般細菌数試験に用います。 ●水の試験でも用いられます。 商品の仕様 ●生培地 ●用途:食品検査用 ●入数:20枚入 ●JANコード:382902515364 【※ご注意ください】商品は代表の画像を使用しています。
6039 円 (税込 / 送料込)

分析・特殊機器/培養機器・容器/培地等Merck クロモカルト エンテロバクターサカザキ寒天培地 微生物学用 クロモカルト(R) 100873 500G 1個 1.00873.0500
Merck クロモカルト エンテロバクターサカザキ寒天培地 微生物学用 クロモカルト(R) 100873 500G 1個
184450 円 (税込 / 送料別)

分析・特殊機器/分離・分析ロシ/分析機器その他ベクトン・ディッキンソン BD Difco(TM) ブリューワー嫌気性菌用寒天培地 1個 227920
ベクトン・ディッキンソン BD Difco(TM) ブリューワー嫌気性菌用寒天培地 1個●嫌気性および微好気性微生物の培養に用います。●粉末培地●用途:嫌気性菌用●質量:500g
23610 円 (税込 / 送料別)

分析・特殊機器/分離・分析ロシ/分析機器その他ベクトン・ディッキンソン BD BBL(TM) BTB乳糖加寒天培地 100枚 1個(1本×100枚入) 251251
ベクトン・ディッキンソン BD BBL(TM) BTB乳糖加寒天培地 100枚 1個(1本×100枚入)●BTB 乳糖加寒天培地は臨床材料から、特にグラム陰性桿菌の分離用に使用します●生培地●用途:腸内細菌用●入数:100枚入
20790 円 (税込 / 送料別)
![アズワン AS ONE 粉末培地 WL普通寒天 10866 6-8814-41 [1445-0098298]](https://thumbnail.image.rakuten.co.jp/@0_mall/daishinshop/cabinet/item/1445-116/1445-0098298.jpg?_ex=128x128)
画像は代表画像です!ご購入時は商品説明等ご確認ください!アズワン AS ONE 粉末培地 WL普通寒天 10866 6-8814-41 [1445-0098298]
納期目安 (メーカーに在庫がある場合)13:30までにご注文の場合約3~7日後出荷(土日祝日を除く)※表示の納期目安はあくまで目安ですのでお約束ではありません。具体的納期は都度お問い合わせください。お取り寄せ品です!ご注文後[商品欠品]及び[商品完売(廃番)]が発生する場合がございます。あらかじめご了承の上ご注文お願いいたします!またご注文の数量、お届け先によって別途送料が発生する場合がございます。その場合当店よりご連絡させていただきますのでご対応お願いいたします。商品未発送の状況でもメーカーによってはキャンセル不可となり場合もございますのでご了承の上ご注文お願いいたします。※記載の商品画像はイメージ(代表)画像ですので画像だけの情報のみでご購入はお控え頂き、必ず記載内容をご確認下さい。・☆☆必ずご覧ください!☆☆・アワズン商品の詳細につきましては「アズワン」ホームページでご覧ください。・大型商品・精密機器等の場合はお届け先が法人名に限らせていただきます!またその場合【代引き不可】となります。・また大型商品の場合車上渡しになる可能性もございます。・商品画像につきましてはカタログ用の代表画像となりますので非常にわかりにくくなっております。また画像の添付間違いも考えられますので、【画像情報のみのご購入はせず、商品情報を合わせてご確認ください】※画像のみ判断での返品対応、その他保証は一切出来ま当社管理番号6-8814-41--検索キーワード--
48444 円 (税込 / 送料込)

★ポイント最大16倍★お気軽にお見積もりご依頼下さい!★ポイント最大16倍★【全国配送可】-小分け包装粉粉末培地 (標準寒天)1箱(40袋入) Merck 型番 5463-J aso 6-8813-03 ●在庫品 納期約 3営業日-【医療・研究機器】
●型番:5463-J●培地名:標準寒天(400mL/包)●適合:水、乳製品その他の検体中の菌数測定●入数:1箱(9g/包×40包入)●小分け包装●※※事業者向け商品です※※ ●広告文責:株式会社コール・ミー 03-3533-9699 ●医療機器登録番号 ●商品品番 aso 6-8813-03 ●JAN ●メーカー型番 5463-J★事業者向け商品です。研究 実験 測定 検査 実験設備 保管 ライフサイエンス 分析 容器 コンテナー 実験器具 材料 備品 滅菌 清掃 安全保護用品 クリーン環境関連機器 ナビス navis アズワン asone axel 介護 病院 クリニック 診療所 グループホーム 訪問看護 訪問介助 居宅 インボイス対応 適格請求書発行事業者 Oversea Shipping EMS FedEx DHL ★お見積りはこちらから★ aso更新日 2025/10/31★月島堂はインボイス対応済!インボイスのご請求書、領収書をご発行可能です。★業界最安値に挑戦!専門店ならではの納得価格。★創業28年の信頼と実績!★多くのお客様に選ばれ、累積受注件数35000件突破!★月島堂は90%以上のお客様にご納得いただいております。★お気軽にお見積もりご依頼下さい★お見積りはこちらから★
8654 円 (税込 / 送料別)

【AS ONE】分析・特殊機器|分析機器その他ベクトン・ディッキンソン 251147 BD BBL(TM) ソルビトール添加マッコンキーII寒天培地 20枚
【アズワン AS ONE】分析・特殊機器 分離・分析ロシ 分析機器その他 ●ソルビトール添加マッコンキーII寒天培地は、グラム陰性桿菌用の選択培地であるマッコンキーII寒天培地の乳糖をソルビトールに置き換えることにより、病原性大腸菌O157とそれ以外のE. coliとを容易に区別できます 商品の仕様 ●生培地 ●用途:腸内細菌用 ●入数:20枚入 ●JANコード:382902511472 【※ご注意ください】商品は代表の画像を使用しています。 【※ご注意ください】0
5269 円 (税込 / 送料別)

【AS ONE】分析・特殊機器|分析機器その他島津ダイアグノスティクス 5701 アキュディアTM サブロー寒天培地 顆粒 300 g
【アズワン AS ONE】分析・特殊機器 分離・分析ロシ 分析機器その他 ●日本薬局方準拠培地 ●真菌用 商品の仕様 ●内容量:300g ●重量:438g ●※保存方法:室温・防湿 ●※有効期限:製造より3年 ●JANコード:4987302057016 【※ご注意ください】商品は代表の画像を使用しています。
6094 円 (税込 / 送料込)

【AS ONE】分析・特殊機器|分析機器その他島津ダイアグノスティクス 51053 アキュレートチョコレート寒天培地-EXII10枚
【アズワン AS ONE】分析・特殊機器 分離・分析ロシ 分析機器その他 ●本培地は、Haemophilus、Neisseriaなどの発育要求性の厳しい菌の分離培養、および増菌培養のために使用する。 ●ゴノコッカス(GC)寒天基礎培地にヘモグロビン末とCLSI M22-A3発育因子を加え、発育支持力を強化した培地である。 商品の仕様 ●包装:10枚 ●貯蔵方法:4~10℃に保存(禁凍結) ●サイズ:W10cm×H10cm×D10cm ●JANコード:4987302510535 【※ご注意ください】商品は代表の画像を使用しています。
2937 円 (税込 / 送料別)

島津ダイアグノスティクス 粉末培地 顆粒タイプ アキュディア™ XM-G寒天培地 300g
包装:300 g使用期限:製造後36ヵ月間貯蔵方法:室温・防湿酵素基質の作用による発色で菌を判定し、鑑別する事ができます。コロニーが発色するため判定が容易です。
22027 円 (税込 / 送料込)

分析・特殊機器/分離・分析ロシ/分析機器その他ベクトン・ディッキンソン BD Difco(TM) 抗生物質培地11(エリスロマイシン-ネオマイシンアッセイ寒天培地) 1個 259310
ベクトン・ディッキンソン BD Difco(TM) 抗生物質培地11(エリスロマイシン-ネオマイシンアッセイ寒天培地) 1個●抗生物質力価検定用培地です。●粉末培地●用途:抗生物質検定・効力確認用●質量:500g
24948 円 (税込 / 送料別)

分析・特殊機器/分離・分析ロシ/分析機器その他ベクトン・ディッキンソン BD BBL(TM) 変法サルモネラ・シゲラ寒天培地/CT-ソルビトール添加マッコンキー寒天培地 LDIP 100枚 1個(1本×100枚入) 251513
ベクトン・ディッキンソン BD BBL(TM) 変法サルモネラ・シゲラ寒天培地/CT-ソルビトール添加マッコンキー寒天培地 LDIP 100枚 1個(1本×100枚入)●本培地は1枚で2種類の培地が併用できる様に組み合わされた便利で効率の良い培地で、糞便検体からSalmonella、Shigella の分離培養に適した変法サルモネラシゲラ寒天培地と病原性大腸菌O157 の分離培養に適したCT- ソルビトール添加マッコンキーII 寒天培地との組み合わせです●生培地(分画培地)●入数:100枚入
28067 円 (税込 / 送料別)
![アズワン AS ONE 粉末培地 XLT4寒天 6-8814-75 [1445-0098324]](https://thumbnail.image.rakuten.co.jp/@0_mall/daishinshop/cabinet/item/1445-116/1445-0098324.jpg?_ex=128x128)
画像は代表画像です!ご購入時は商品説明等ご確認ください!アズワン AS ONE 粉末培地 XLT4寒天 6-8814-75 [1445-0098324]
納期目安 (メーカーに在庫がある場合)13:30までにご注文の場合約3~7日後出荷(土日祝日を除く)※表示の納期目安はあくまで目安ですのでお約束ではありません。具体的納期は都度お問い合わせください。お取り寄せ品です!ご注文後[商品欠品]及び[商品完売(廃番)]が発生する場合がございます。あらかじめご了承の上ご注文お願いいたします!またご注文の数量、お届け先によって別途送料が発生する場合がございます。その場合当店よりご連絡させていただきますのでご対応お願いいたします。商品未発送の状況でもメーカーによってはキャンセル不可となり場合もございますのでご了承の上ご注文お願いいたします。※記載の商品画像はイメージ(代表)画像ですので画像だけの情報のみでご購入はお控え頂き、必ず記載内容をご確認下さい。・☆☆必ずご覧ください!☆☆・アワズン商品の詳細につきましては「アズワン」ホームページでご覧ください。・大型商品・精密機器等の場合はお届け先が法人名に限らせていただきます!またその場合【代引き不可】となります。・また大型商品の場合車上渡しになる可能性もございます。・商品画像につきましてはカタログ用の代表画像となりますので非常にわかりにくくなっております。また画像の添付間違いも考えられますので、【画像情報のみのご購入はせず、商品情報を合わせてご確認ください】※画像のみ判断での返品対応、その他保証は一切出来ま当社管理番号6-8814-75--検索キーワード--
49500 円 (税込 / 送料込)

生培地生培地 ポアメディア CP加ポテトデキストロース寒天/61-9627-94
生培地 ポアメディア CP加ポテトデキストロース寒天/61-9627-94 生培地 内容量:10枚 真菌の増殖 ■分離 ■菌数測定用 CPが細菌を抑制 商品コード39078766220商品名生培地 ポアメディア CP加ポテトデキストロース寒天/61-9627-94型番8-MR31※他モールでも併売しているため、タイミングによって在庫切れの可能性がございます。その際は、別途ご連絡させていただきます。※他モールでも併売しているため、タイミングによって在庫切れの可能性がございます。その際は、別途ご連絡させていただきます。
2373 円 (税込 / 送料込)

★8/4-11 P最大27倍★お気軽にお見積もりご依頼下さい!★ポイント最大16倍★【全国配送可】-ステンレス寒天 トヨ型 半月 エムテートリマツ 型番 JAN 4967151115129 aso 63-1423-95 ●在庫品 納期約 5営業日-【医療・研究機器】
●サイズ:外寸371×54×高さ40mm、内寸365×47×深さ36mm●コード番号:20238001 ●広告文責:株式会社コール・ミー 03-3533-9699 ●医療機具登録番号 ●商品品番 aso 63-1423-95 ●JAN 4967151115129 ●メーカー型番 ★事業者向け商品です。研究 実験 測定 検査 実験設備 保管 ライフサイエンス 分析 容器 コンテナー 実験器具 材料 備品 滅菌 清掃 安全保護用品 クリーン環境関連機器 ナビス navis アズワン asone axel Oversea Shipping EMS FedEx DHL ★お見積りはこちらから★ aso更新日 2025/08/01★月島堂はインボイス対応済!インボイスのご請求書、領収書をご発行可能です。★業界最安値に挑戦!専門店ならではの納得価格。★創業28年の信頼と実績!★多くのお客様に選ばれ、累積受注件数35000件突破!★月島堂は90%以上のお客様にご納得いただいております。★お気軽にお見積もりご依頼下さい★お見積りはこちらから★
718 円 (税込 / 送料別)

栄研化学生培地 ポアメディア WYOα寒天 1パック (10枚入) E-MR70
●レジオネラ属菌の選択分離用●生培地●内容量:10枚●事業者向け商品です。リニューアルに伴い、パッケージ・内容等予告なく変更する場合がございます。予めご了承ください。広告文責:楽天グループ株式会社050-5212-8316
3850 円 (税込 / 送料別)

【AS ONE】分析・特殊機器|分析機器その他ベクトン・ディッキンソン 265430 BD Difco(TM) APT寒天培地
【アズワン AS ONE】分析・特殊機器 分離・分析ロシ 分析機器その他 ●食品中の乳酸桿菌の培養および菌数計算用の培地です。 商品の仕様 ●粉末培地 ●用途:乳酸菌用 ●質量:500g ●JANコード:382902654308 【※ご注意ください】商品は代表の画像を使用しています。 【※ご注意ください】0
23870 円 (税込 / 送料別)


